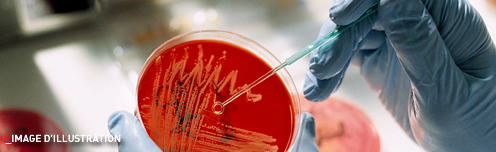

La France est «complètement larguée» au niveau de la recherche médicale
La France est «complètement larguée» au niveau de la recherche médicale
Le professeur Philippe Even, ancien doyen de la faculté de médecine Necker livre un diagnostic sans appel…
«On est complètement largué»: l’ancien doyen de la faculté de médecine Necker, Philippe Even, alerte sur le déclin de la recherche biologique et médicale française, tirant à boulets rouges sur «un système terrifiant de contraintes» et d’«immobilisme».
«Ils sont asphixiés»
Son dernier livre de plus de 500 pages, La recherche biomédicale en danger, tombe comme un pavé dans la mare, éclaboussant politiques, agences et instituts. «Je fais partie d’un groupe d’hommes assez rares qui, ayant acquis la liberté complète et l’indépendance, et après une expérience de près de 50 ans dans le métier, peuvent à juste titre alerter sur ce qu’ils voient, sur ce que les autres voient aussi mais ne disent pas», explique le Pr Even dans un entretien à l’AFP.
«Le flux de la science coule à grande vitesse comme un torrent, et nous on est là, assis sur un pliant au bord de la rivière, avec notre ligne à bouchon tricolore. De temps en temps on attrape un poisson qui passe, mais on n’est pas sur la rivière. On ne progresse pas en même temps qu’elle.» Aujourd’hui président de l’Institut Necker, le médecin dédouane les chercheurs, «vraiment très bons, et en plus désintéressés, passionnés». «Mais ils sont dans un système, un réseau qui les contraint de tous côtés, ils sont asphyxiés», affirme-t-il.
Avec son franc-parler redoutable, c’est l’Etat qu’il cloue au pilori en premier lieu. «Partout où l’Etat est présent comme puissance dominante avec sa bureaucratie immobile, sa gérontocratie, ses hiérarchies, sa paperasserie, ses contraintes et sa pauvreté, il ne se passe rien», assène-t-il.
«Tout se passe en coulisse»
Peu nombreux sont ceux qui trouvent quelque grâce à ses yeux: l’ancien ministre de la Recherche Claude Allègre et aujourd’hui Valérie Pécresse. «Tout se passe dans la coulisse», clame-t-il, dénonçant la toute puissance des Grands Corps – X, Mines, Ponts, CEA, CNES – «qui ont infiltré toutes les structures de l’état, et qui prennent de facto toutes les grandes décisions d’investissement sans aucun contrôle».
Trois projets -ITER à Cadarache, la station spatiale habitée, le Laser Mégajoule- «croquent à eux seuls autant que toute la recherche biologique et médicale, pointe-t-il. L’Etat croit que la recherche ça se programme, alors que la recherche c’est toujours une surprise. S’il n’y a pas de surprise, ce n’est plus de la recherche». Et de développer l’exemple du virus VIH, responsable du sida, dont la découverte en 1983 a valu aux Français Françoise Barré-Sinoussi et Luc Montagnier le Prix Nobel de Médecine en 2008.
«A ce moment là des chercheurs jeunes, autonomes, audacieux, ont mis dans le mille plusieurs fois de suite. Depuis le jour où l’Etat est entré là dedans, il ne se passe plus rien». L’Agence nationale de recherche sur le sida (ANRS), «a stérilisé la recherche», assène-t-il.
«Un système terrifiant»
«Et là ce n’est pas une opinion, même si ce livre est plein d’opinions, bien sûr, et parfois d’humeurs. Ce sont des faits, des chiffres», assure-t-il, soulignant que ses accusations s’appuient sur l’analyse des publications scientifiques. Le véritable critère d’évaluation à ses yeux. A 78 ans, le Pr Even prend le parti des jeunes chercheurs, «mis complètement sous tutelle», mal payés mais aussi sans aucun espace de liberté où développer un projet.
«Ils sont dans un système terrifiant de contraintes, parce que le pouvoir est aux vieux, qui tiennent tout, qui assurent l’immobilisme».
La Recherche biomédicale en danger du Pr Philippe Even, Le Cherche midi, 534 p., 23,50 euros.
